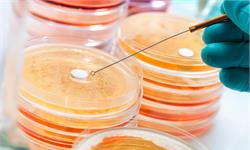

虽说疫情总是带来很多不确定性,但作为世界第二大经济体的中国,正努力以责任与担当,为全球市场带来更多的确定性。
近日,商务部、海南省人民政府共同宣布,第二届消博会将于7月26日至30日在海口举行。与首届消博会相比,第二届消博会将新增部分细分行业的全球头部品牌,重点国别和地区的参与度也将变得更高。截至目前,已有58个国家和地区的企业和品牌确认参展。已成功举办四届的上海进博会,也将按原定计划11月如期举行。据商务部新闻发言人透露,目前进博会各项筹备工作进展顺利,其中,企业商业展签约面积已超过规划面积的75%,世界500强和行业龙头企业数量超过250家。
刚刚过去的5月份,我国出口(以美元计)以16.9%的同比增速大超市场预期,而单月环比更是创下有数据记录以来的同期最高。这其中,有对比基数较低、外部需求回升的原因,也有国内疫情得到有效控制、物流及供应链产业链快速恢复等因素,这些共同推高了5月份出口增速。
不过,仅凭单月出口数据的反弹,并不能说明我国外贸已经走出了下行拐点,也不宜简单地做出外贸重返高增长轨道的判断。事实上,5月份出口增长更多的是一种恢复性增长。与此同时,5月份进口增速也超出预期,但这个超预期的背后,能源进口仍是主要贡献力量,如果剔除能源这一权重,那么5月份进口仍延续了此前的负增长,表明当前内需疲软的态势尚未有效扭转。
综合来看,当前我国外贸发展依然面临着众多风险挑战,诸如外需市场的低迷不振,疫情对供应链产业链的冲击,输入型通胀压力的持续加大,发达经济体积极财政货币政策的退出等。其中任何一个环节出现问题,都可能带来整个外贸行业的“蝴蝶效应”。在此背景下,稳外贸仍应是下半年我国稳增长政策的重点所在。
在正视困难挑战的同时,也要看到,我国外贸发展仍有着较为明显的竞争优势。除传统的制造业优势外,3月份以来的人民币贬值、中美关税可能实施部分豁免等,均有望对后续出口形成利好。更重要的是,我国外贸结构的持续优化提升,增强了外贸发展的韧性,巩固了我国外贸在国际上的地位,也回应了社会上有关出口替代的担忧。
有观点认为,东盟地区正逐步取代我国在全球产业链供应链的地位。客观来看,受劳动力成本不断提高的影响,我国一些劳动密集型产业确实存在向东盟国家转移的现象。但更要看到,产业转移的背后,还包含着我国与东盟之间更趋紧密的产业链合作――东盟地区的加工制造业很大程度上依靠来自我国的中间品,这也意味着我国与东盟之间的贸易往来,更多的是供应链上下游的合作关系,而不是单纯的贸易取代。
需要指出的是,随着国内疫情防控形势总体向好,生产需求逐步恢复,外贸物流逐步改善,前期积压的外贸订单加快释放,短期内将推高外贸增速回升,但考虑到去年同期基数逐步抬高等因素影响,下半年我国外贸增速大概率会出现回落。对此,一方面,要继续深化落实现有的稳外贸各项政策举措,进一步为外贸企业纾困解难;另一方面,要立足外贸长远发展的需要,在促进内外贸高质量一体化发展、挖掘RCEP等区域合作贸易潜力等方面聚焦发力,持续推动外贸保稳提质。 (顾阳 来源:经济日报)
未经允许不得转载:奥鸟视频-全球短视频资讯平台 » 外贸仍要保稳提质
奥鸟视频-全球短视频资讯平台